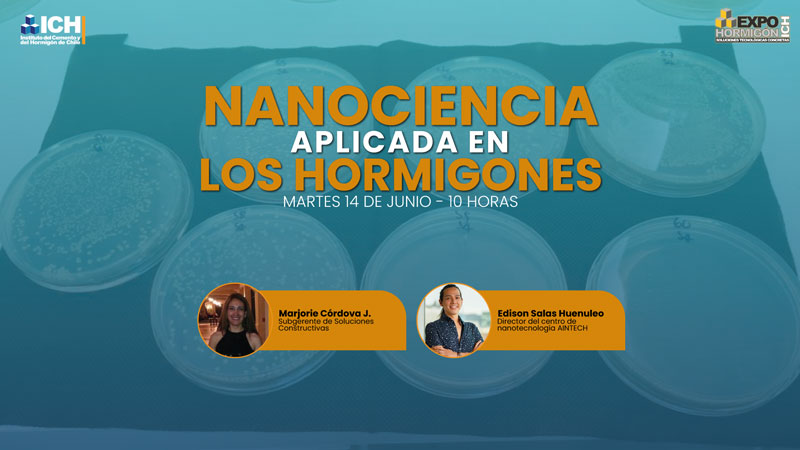
descanso

En este espacio único, encontrarán todos los webinar realizados y transmitidos por el Instituto del Cemento y Hormigón de Chile, ordenados en transmisiones en vivo o eventos pasados, accediendo de manera rápida y fácil a estos eventos online en los que participan destacados profesionales del mundo de la construcción con hormigón.